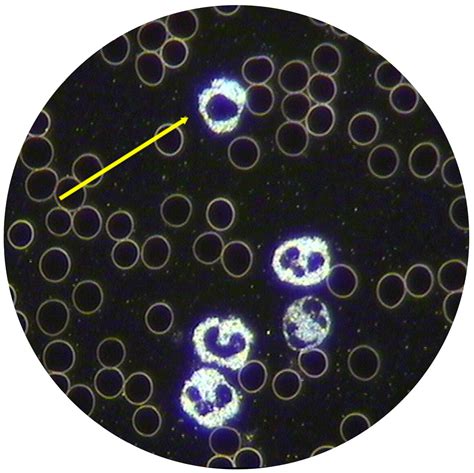

OSC: Live Blood Analysis In Surabaya
OSC: Live Blood Analysis in Surabaya
Hey guys! Ever wondered what’s really going on inside your body? We’re talking about the nitty-gritty, the stuff floating around in your bloodstream. Well, get ready, because we’re diving deep into the world of OSC (Ozone Therapy Surabaya Center) and their amazing live blood analysis services right here in Surabaya. This isn’t your typical blood test, folks. This is a real-time, up-close look at your blood cells, giving you insights that can totally change how you approach your health. Imagine seeing your own red blood cells, white blood cells, and platelets on a screen, moving and grooving! It’s a game-changer, and OSC Surabaya is bringing it to you.
Table of Contents
So, what exactly is live blood analysis, you ask? Think of it as a super-powered microscope connected to a screen. A tiny drop of your blood is taken, placed on a slide, and then analyzed under this powerful microscope. The magic happens when you get to see your blood cells live . This means you’re not just looking at a snapshot of your blood from days ago; you’re seeing it as it is right now . This dynamic view allows practitioners to spot things that might be missed in a traditional lab test. They can observe the shape, size, and even the movement of your cells. Are your red blood cells clumped together? Are your white blood cells looking sluggish? These are the kinds of clues that live blood analysis can reveal, offering a unique perspective on your overall health status. It’s all about getting a clearer picture of your internal environment and identifying potential imbalances early on. At OSC Surabaya, they use this cutting-edge technology to provide a more comprehensive health assessment, empowering you with knowledge about your body that you might not have otherwise.
The OSC Surabaya Difference: More Than Just a Blood Test
What makes OSC Surabaya stand out when it comes to live blood analysis? Well, for starters, they’re not just about taking a sample and giving you a report. They’re focused on understanding what they see and how it relates to your specific health journey. The team at OSC Surabaya are dedicated to providing a holistic approach to health , and live blood analysis is a crucial part of that. They believe in empowering individuals with knowledge about their own bodies, and this technique is a powerful tool for education. When you have your live blood analysis done at OSC, you’re not just a patient; you’re an active participant in understanding your health. You’ll see the visual evidence for yourself, and the experienced practitioners will guide you through what you’re observing. They’ll explain the significance of different cell characteristics and how they might be impacting your well-being. This personalized approach means that the insights gained are directly relevant to you, and the recommendations that follow are tailored to your unique needs. It’s this commitment to education and personalized care that truly sets OSC Surabaya apart. They aim to make health information accessible and actionable, so you can make informed decisions about your lifestyle and well-being. Forget confusing jargon and complex reports; at OSC, they make it simple and visual, helping you grasp the state of your health in a way that resonates.
Unveiling Your Health: What Can Live Blood Analysis Show?
So, what kind of juicy details can you expect to uncover with live blood analysis at OSC Surabaya ? Get ready, because it’s pretty mind-blowing! OSC uses this method to give you a real-time snapshot of your health , and it can reveal a surprising amount about what’s going on under the surface. We’re talking about looking at your red blood cells – those little guys responsible for carrying oxygen. Are they nice and round and floating freely? Or are they sticky and clumped together, making it harder for oxygen to get where it needs to go? Live blood analysis can show you this! It can also highlight issues with white blood cells, your body’s defense system. Are they looking active and ready to fight off invaders, or do they seem a bit… well, tired? Beyond cell shape and function, this analysis can offer clues about your nutritional status . For instance, deficiencies in certain vitamins or minerals might affect the appearance of your blood cells. It can also give insights into potential issues like inflammation, oxidative stress, and even the presence of certain toxins in your system. Think of it as a visual warning system. If your blood cells are showing signs of distress, it’s a cue that your body might need some extra support in specific areas. OSC Surabaya helps you interpret these visual cues, connecting the dots between what you see on the screen and how you might be feeling. It’s about getting a proactive understanding of your health, identifying potential areas of concern before they become bigger problems. This isn’t about scaring you; it’s about empowering you with information so you can take control of your well-being.
The Power of Prevention: How OSC Surabaya Empowers You
One of the most powerful aspects of live blood analysis at OSC Surabaya is its emphasis on prevention . Guys, we all know prevention is better than cure, right? But how often do we actually put that into practice? OSC Surabaya makes it easier by giving you a visual roadmap of your health . Instead of waiting for symptoms to pop up, you can get a proactive look at what might be brewing. This early detection is key. Imagine seeing potential issues with your blood cells long before you experience any discomfort or serious health problems. This gives you a massive advantage. You can then work with the experts at OSC to make targeted lifestyle changes, dietary adjustments, or consider specific therapies that can address these potential issues at their root. It’s about getting ahead of the game! By understanding the current state of your blood, you can make informed decisions that support your body’s natural healing capabilities. OSC Surabaya doesn’t just tell you what’s wrong; they help you understand why it might be happening and guide you on the path to improvement. This proactive approach can lead to more energy, better overall well-being, and a reduced risk of developing chronic conditions down the line. It’s a truly empowering way to take charge of your health, turning potential worries into actionable steps towards a healthier you. They are committed to helping you achieve optimal health through informed choices and consistent care.
Embarking on Your Health Journey with OSC Surabaya
Ready to take the plunge and see what your blood has to tell you? Getting started with live blood analysis at OSC Surabaya is straightforward and incredibly rewarding. The first step is usually to book an appointment. You can reach out to them directly to find a time that works for your schedule. When you arrive, you’ll likely have a consultation where the practitioners will discuss your health history and any concerns you might have. This helps them tailor the analysis and interpretation to your individual needs. Then comes the exciting part: the live blood analysis itself! As mentioned, it involves a simple finger prick to obtain a small blood sample. This sample is immediately placed on a slide and viewed under a high-powered microscope, with the magnified images displayed on a screen for you to see. The practitioners at OSC Surabaya will guide you through the observation, explaining what you’re seeing in clear, understandable terms. They’ll point out the different types of blood cells, their characteristics, and what these observations might mean for your health. Following the analysis, you’ll typically receive a detailed explanation and personalized recommendations. This might include dietary advice, lifestyle changes, or suggestions for further therapies. The goal is to provide you with a comprehensive understanding of your health status and a clear plan for improvement. It’s about equipping you with the knowledge and tools you need to make positive changes. So, don’t hesitate! Embarking on this health journey with OSC Surabaya is an investment in your future well-being. It’s a chance to gain incredible insights and take a proactive stance towards a healthier, more vibrant life. Give them a call and schedule your appointment today – your body will thank you for it!
Understanding the Technology Behind Live Blood Analysis
Let’s get a little techy for a sec, guys, because understanding the science behind live blood analysis at OSC Surabaya really highlights how revolutionary this method is. At its core, this technique utilizes high-powered dark-field microscopy . Now, what’s that, you ask? Unlike regular microscopy where light shines through the specimen, dark-field microscopy illuminates the specimen from the sides . This creates a bright image of the specimen against a dark background, making even the smallest and most transparent structures, like blood cells, incredibly visible. This is crucial because it allows us to see the cells in their natural, unstained state, offering a much more accurate picture of their living condition. The microscope is typically equipped with a high-resolution camera and linked to a monitor, so you and the practitioner can see the live feed together. This visual aspect is what makes the analysis so engaging and understandable. You’re not just being told what’s happening; you’re seeing it happen in real-time. The magnification levels used are significant, allowing for detailed observation of individual blood cells – their size, shape, internal structures, and how they interact with each other. This level of detail is what enables the identification of subtle abnormalities that might be indicative of underlying health issues. At OSC Surabaya, they invest in reliable and advanced equipment to ensure the accuracy and clarity of the analysis. It’s this cutting-edge technology, combined with the expertise of their practitioners, that makes live blood analysis such a potent tool for health assessment and education. It’s a fascinating blend of biology and technology, all aimed at giving you the clearest possible insight into your internal landscape. The ability to observe cells in their dynamic, living state provides information that static, stained samples simply cannot capture. It’s a truly remarkable way to gain a deeper understanding of your body’s inner workings.
Benefits Beyond the Obvious: What Else Can You Gain?
We’ve talked a lot about seeing your blood cells and understanding potential issues, but the benefits of live blood analysis at OSC Surabaya extend far beyond just a visual inspection. One of the biggest advantages is the educational component . When you see your own blood cells on the screen, it makes health concepts tangible and personal. It’s one thing to read about inflammation or nutrient deficiencies; it’s another entirely to see visual evidence of how these factors might be affecting your body. This direct experience fosters a greater sense of responsibility and motivation to make positive changes. Furthermore, live blood analysis can be a fantastic tool for monitoring progress . If you’re undergoing a particular health protocol or making lifestyle changes, subsequent live blood analyses can help track improvements. Seeing your blood cells become healthier over time is incredibly encouraging and validates the effectiveness of your efforts. It allows for adjustments to be made to your plan as needed, ensuring you’re always moving in the right direction. Another significant benefit is the identification of potential imbalances that may not be apparent in standard blood tests . Traditional tests often focus on specific markers and can miss the broader picture of cellular health. Live blood analysis can highlight issues like dehydration, yeast overgrowth, or the presence of certain types of parasites, which might otherwise go undetected until they manifest as more serious symptoms. OSC Surabaya leverages this comprehensive view to offer more holistic and proactive health strategies. It’s about understanding the interconnectedness of your body’s systems and addressing root causes rather than just symptoms. This approach can lead to profound improvements in energy levels, immune function, and overall vitality. By providing such a detailed and dynamic view of your internal environment, OSC Surabaya empowers you to take a more informed and active role in managing your health, leading to a greater sense of well-being and longevity.
Connecting Live Blood Analysis with Overall Wellness Goals
Guys, it’s super important to remember that live blood analysis at OSC Surabaya isn’t a magic bullet, but it’s an incredible tool that fits perfectly into your broader wellness goals . Think of it as one piece of a bigger puzzle. When you’re aiming for better health, whether that’s more energy, better sleep, stronger immunity, or managing a chronic condition, live blood analysis provides invaluable data to guide you. For instance, if your goal is to boost your energy levels, seeing your red blood cells effectively carrying oxygen during a live analysis can be a powerful indicator. If they’re not, it pinpoints a potential area to focus on, like improving iron levels or addressing factors that cause cell clumping. Similarly, if you’re working on strengthening your immune system, observing your white blood cells in action can offer insights into their activity and responsiveness. OSC Surabaya uses these findings to help you tailor your diet, supplement regimen, and lifestyle choices to align with your specific wellness objectives. It’s not just about fixing problems; it’s about optimizing your body’s functions to achieve peak performance. This personalized approach ensures that your efforts are targeted and effective. By understanding the unique landscape of your blood, you can make more informed decisions about everything from the foods you eat to the stress management techniques you employ. OSC Surabaya aims to be your partner in achieving these goals, providing the insights necessary to navigate your health journey with confidence and clarity. It’s about integrating this advanced diagnostic tool into a comprehensive strategy for lifelong health and vitality, ensuring you’re not just surviving, but truly thriving.
Testimonials and Success Stories from OSC Surabaya Clients
Don’t just take our word for it, guys! The real magic of live blood analysis at OSC Surabaya is best seen through the experiences of people who have benefited from it. While we can’t share specific client names here for privacy reasons, the stories we hear are consistently inspiring. Many clients come to OSC Surabaya feeling fatigued, sluggish, or dealing with unexplained health issues. After undergoing live blood analysis, they often report a profound “aha!” moment when they see their own blood cells and begin to understand the underlying factors contributing to their discomfort. For example, a client experiencing persistent digestive issues might discover through the analysis that certain dietary components are affecting their blood cell integrity. Armed with this knowledge, they can work with the OSC team to make targeted dietary changes, leading to significant relief. Another common success story involves individuals looking to boost their immune system. Seeing their white blood cells appear less robust might prompt them to focus on specific nutrients or lifestyle adjustments that enhance immune function, resulting in fewer sick days and a greater sense of well-being. Parents have also found immense value in using live blood analysis to understand their children’s health on a deeper level, identifying potential nutritional gaps or sensitivities early on. The common thread across these testimonials is the feeling of empowerment. Clients often express gratitude for the clear, visual explanations provided by the practitioners at OSC Surabaya , which demystify complex health concepts. They appreciate the non-judgmental and supportive environment, and the actionable advice they receive. The consistent feedback highlights how live blood analysis at OSC provides not just information, but a tangible pathway towards improved health and a renewed sense of vitality. These success stories underscore the effectiveness and transformative potential of this unique health assessment tool. It’s proof that understanding your internal landscape can lead to remarkable positive changes in your life.
Frequently Asked Questions About Live Blood Analysis
We get it, guys, diving into a new health technology can bring up a bunch of questions! So, let’s tackle some of the most common ones regarding live blood analysis at OSC Surabaya .
Is live blood analysis painful?
Absolutely not! The procedure involves a simple finger prick, which is no more painful than a typical blood glucose test. It’s a quick and minimally invasive way to get a wealth of information.
How long does a live blood analysis session take?
Generally, a session including consultation and the analysis itself takes about 30 to 60 minutes. The actual microscopic viewing is quite dynamic and efficient.
Can live blood analysis diagnose diseases?
It’s important to understand that live blood analysis is primarily an educational and observational tool. It provides insights into cellular health and potential imbalances, but it’s not a diagnostic tool in the same way as conventional medical tests. Diagnosis should always be made by a qualified healthcare professional. However, the insights gained can be invaluable information for your doctor.
What should I do after my live blood analysis?
Following your analysis at OSC Surabaya , you’ll receive personalized recommendations. These might include dietary changes, lifestyle adjustments, or suggestions for further therapies. The key is to follow the guidance provided and integrate the recommended changes into your daily routine for optimal results.
How often should I have a live blood analysis?
The frequency depends on your individual health goals and status. Your practitioner at OSC Surabaya will advise you on the best schedule for follow-up analyses, often recommending them periodically to monitor progress or assess the effectiveness of interventions.
Can I see my blood cells myself?
Yes! One of the most engaging aspects of the process is that you get to view your blood cells on a screen in real-time, guided by the practitioner. It’s a fantastic way to truly understand what’s being discussed.
These FAQs should help clarify any immediate concerns you might have. Remember, OSC Surabaya is there to guide you every step of the way, making this innovative health assessment accessible and beneficial for everyone seeking to improve their well-being.
Conclusion: Taking Control of Your Health with OSC Surabaya
So, there you have it, folks! Live blood analysis at OSC Surabaya offers a fascinating, visual, and deeply informative way to understand your health from the inside out. It’s a proactive approach that moves beyond guesswork, providing real-time insights into your cellular health that can empower you to make significant positive changes. Whether you’re looking to boost your energy, improve your immunity, or simply gain a better understanding of your body’s inner workings, OSC Surabaya is your go-to resource. They combine cutting-edge technology with expert guidance to offer a truly personalized health assessment. Don’t wait for problems to arise; take advantage of this powerful tool to get ahead of the curve. Investing in live blood analysis with OSC Surabaya is an investment in your long-term well-being. It’s about gaining knowledge, taking control, and embarking on a journey towards a healthier, more vibrant you. Ready to see what your blood has to say? Reach out to OSC Surabaya today and discover the incredible potential of live blood analysis for your health!